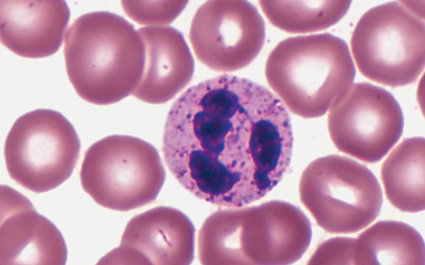
<p>Characteristics of Neutrophils  &nbsp;</p>
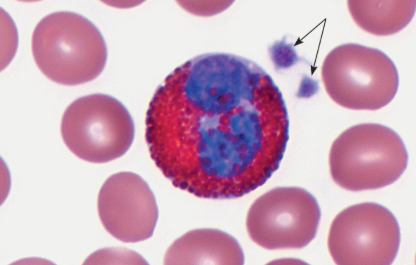
<p>Characteristics of Eosinophils </p>
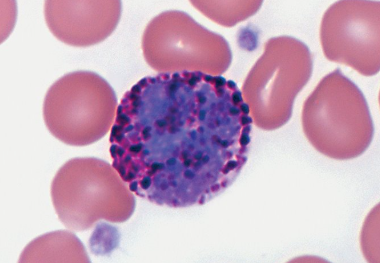
<p>Characteristics of Basophils </p>
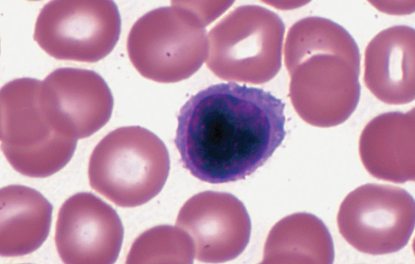
<p>Characteristics of Lymphocyte </p>

1/54
Looks like no tags are added yet.
Name | Mastery | Learn | Test | Matching | Spaced | Call with Kai |
|---|
No analytics yet
Send a link to your students to track their progress
What are the functions of blood?
Transports substances throughout the body
Maintains homeostasis
Distributes heat
Transports nutrients and oxygen to the body cells, and removes metabolic wastes & carbon dioxide
What is the normal blood pH?
7.35-7.45
What are considered the formed elements of the blood?
Red blood cells, white blood cells, and platelets.
Plasma makes up how much of the blood volume?
55%
What’s the usual percentage of the formed elements in the blood?
45%
An average-sized adult has a blood volume of?
5 liters.
What is the percentage of formed elements in the blood called, and what’s it made up most of?
Hematocrit, and it’s mostly made of red blood cells.
Why can’t Red blood cells reproduce?
They dispose of their nuclei and most of their organelles during their development, and cannot produce proteins.
What is hematopoiesis?
Creation of new blood cells from hemocytoblasts; occurs in the red bone marrow.
What are hemocytoblasts?
Hematopoietic stem cells
What metal is necessary for the formation of hemoglobin?
Iron; which is cycled back to red bone marrow to synthesize new RBC.
What happens to damaged/old RBC and their products?
Macrophages in the liver & spleen phagocytize damaged RBC
Hemoglobin from damaged RBC, converted into heme & globin
Heme → iron and the pigment biliverdin → bilirubin, both pigments are excreted in bile
Globin → amino acids, & is reused.
What is the Red blood cells’ function?
Respiratory gas transport
What is the white blood cells function?
Fighting infection by leaving the bloodstream; also does diapedesis.
Diapedesis
WBC (leukocytes) squeezes between cells of wall of small blood vessels
What are the platelets’ function?
Stopping bleeding, assists in repairing damaged blood vessels by adhering to broken edges
What is plasma’s function?
liquid matrix; transports nutrients and gases, regulates fluid and electrolyte balance, and maintains optimal pH
What are the different types of white blood cells?
Granulocytes & Agranulocytes
Granulocytes:
Granular cytoplasm
Short life span (12hr)
Types: Neutrophils, Eosinophils, Basophils
Agranulocytes:
Do not have granular cytoplasm
Longer life-span
Types: Monocyte, Lymphocyte
Characteristics of Neutrophils Â
Granulocyte
Fine, purple staining cytoplasmic granules
Nucleus has 2-5 lobes; comprised of 50-70%
Strong phagocytes
Characteristics of Eosinophils
Granulocyte
Coarse granules, stains deep red
Bilobed nucleus; makes up 1 to 3% of circulating leukocytes
Kill certain parasites and moderates inflammation
Characteristics of Basophils
Granulocyte
Fewer granules than eosinophils
Bilobed/S-shaped nucleus, obscured by dark, blue-stained granules stain
Accounts for <1% of leukocytes
Promotes inflammation by secreting heparin and histamine

Characteristics of Monocytes
Agranulocytes
Largest circulating blood cells
Variably shaped nuclei, makes up 3-9% of circulating leukocytes
Lifespan of weeks to months
Strong phagocytes; migrates to some tissues and differentiates into macrophages
Characteristics of Lymphocyte
Agranulocytes
Long-lived (many years)
Smallest of WBC; has large-round nucleus
Accounts for 25 to 33% of circulating leukocytes
Responsible for immunity
Attacks certain foreign pathogens; types includes: B cells, T cells, and NK cells
What conditions cause abnormal WBC counts?
Illness, leukocytosis, leukopenia
Thrombocytosis
Leads to abnormal platelet levels
Causes high platelet count
Caused by infection or genetic defect.
Thrombocytopenia
Causes abnormal platelet levels
Low platelet count
Caused by genetic condition, leukemia, radiation, some medications, toxic chemicals, excess alcohol, certain pathogens, certain autoimmune diseases
Increases risk of internal bleeding
What is plasma?
Clear, straw-colored liquid part of blood
Hemostasis
Is the stoppage of bleeding
There are 3 processes to prevent/slow blood loss: vascular spasm/vasospasm, platelet plug formation, blood coagulation.
Vascular spasm/vasospasm
Cutting a small blood vessel causes the muscle in its walls to contract
Decreases the blood loss at the site of injury
Serotonin is released at that time to constrict smooth muscle in blood vessel walls

Platelet Plug Formation
Platelets adhere to the exposed edges of damaged blood vessels
Forms a network with spiny processes protruding from their membranes
Platelets stick to eachother, forming a platelet plug at the site of a break in a blood vessel
Effective on a small vessel
Blood Coagulation
Most effective hemostasis
Series of chemical reactions cause blood clot
The response is temporary, aiding in minimizing blood loss and returning to a homeostatic internal environment.
What are the four ABO blood types?
A, B, AB, O
Blood Type A’s Antigens
A
Blood Type A’s Plasma Antibodies
Anti-B
Blood Type B’s RBC Antigens
B
Blood Type B’s Plasma Antibodies
Anti-A
Blood Type AB’s RBC Antigens
A & B
Blood Type AB’s Plasma Antibodies
Neither anti-A nor anti-B
Blood Type O’s RBC Antigens
Neither A nor B
Blood Type O’s Plasma Antibodies
Both anti-A and anti-B
What is an abnormal clot formation called?
A thrombus
What conditions can a thrombus lead to?
Coronary thrombosis, pulmonary embolism, infarction, atherosclerosis
What is Coronary thrombosis?
Clot in a vessel that supplies the heart
What is Pulmonary embolism?
Traveling blood clot that blocks part of a lung
Infarction
Clot that blocks blood flow and kills tissue supplied by that vessel; myocardial infarction is a heart attack.
Atherosclerosis
Build up of fatty deposits in walls of arteries can sometimes lead to abnormal formation of clots
What blood type is considered the universal recipient?
Blood Type AB
What blood type is considered the universal donor?
Blood type O
What is Rh factor?
The inherited protein found on the surface of RBCs. Can be positive or negative.
What is erythoblastosis fetalis/hemolytic disease of the fetus?
When a pregnant woman has the opposite Rh factor to her fetus, and produces antibodies that would harm her future fetus.
Aggulation
clumping;
Antigen
a molecule that evokes an immune response
Antibody
a protein produced by the immune system to attack a specific antigen not found on the person’s own cells.